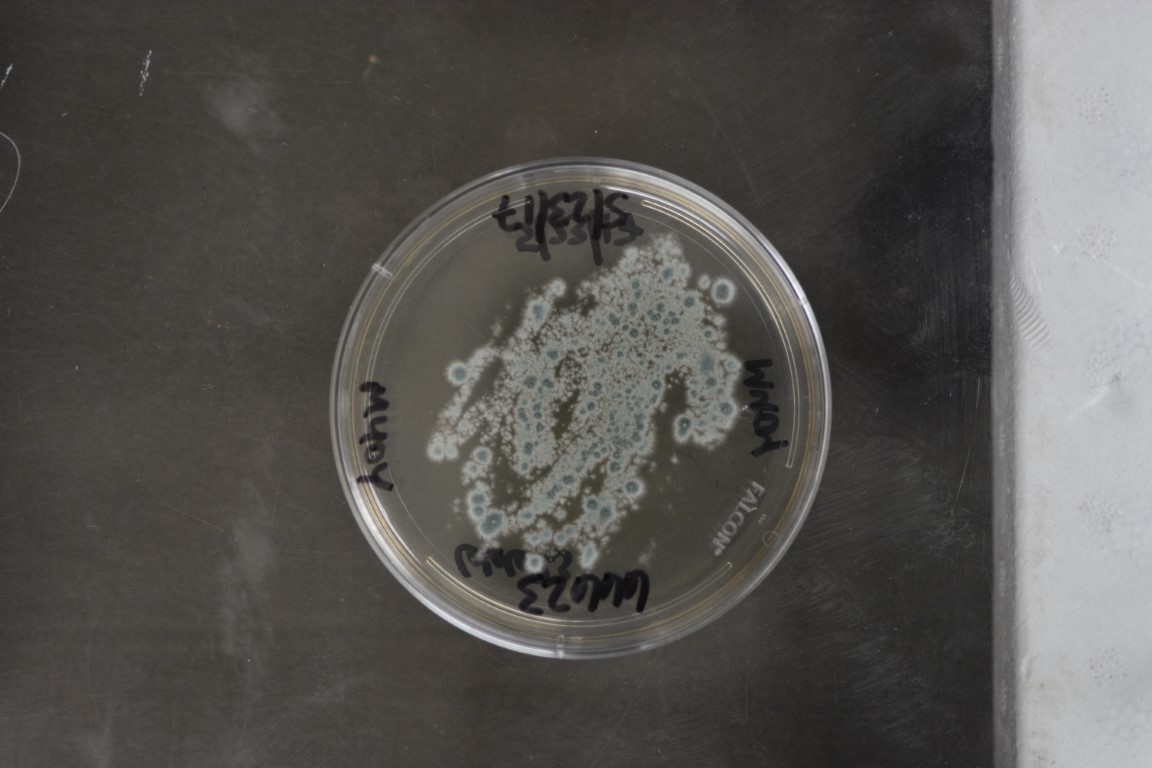
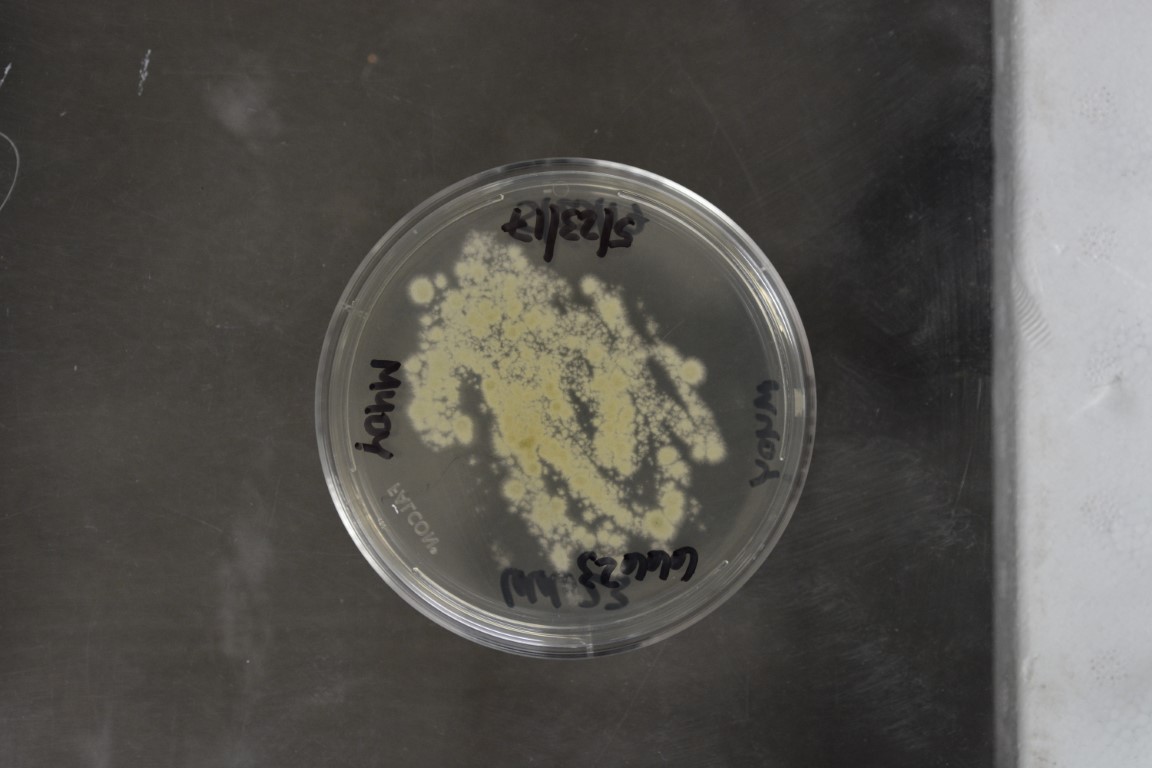

Aspergillus tardicrescens
NRRL 66623(Type Strain)
Accession numbers in other collections:CCF 5529
Source:Vit Hubka Charles University in Prague
Isolated from(substrate):Museum piece(measuring table),2014,unknown isolator
Substrate location:Alpen aan de Rijn,The Netherlands
Growth media:M40Y(Harold's Agar)(number 19)
Optimum growth temperature:25C
Strain images:
NRRL_66623_19_reverse.JPG

NRRL_66623_19_top.JPG

NRRL66623